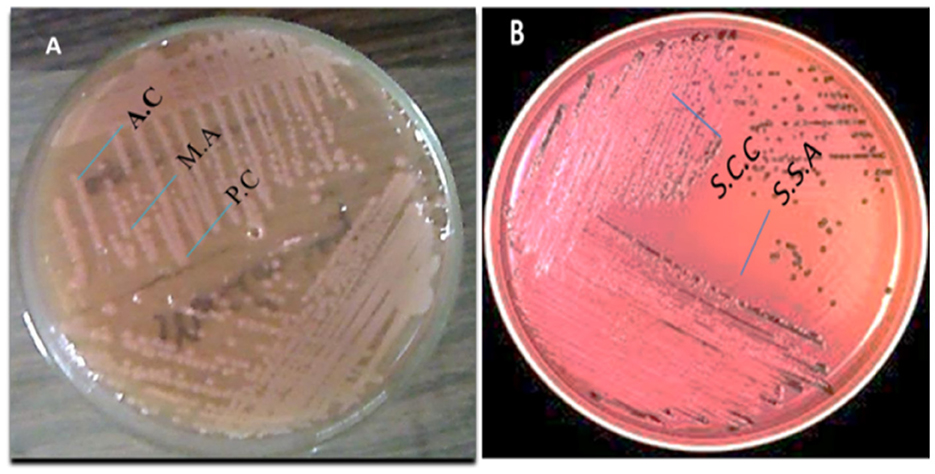

- 1Key Laboratory of Veterinary Pharmaceutical Development, Ministry of Agriculture, Lanzhou, China
- 2Key Laboratory of New Animal Drug Project of Gansu Province, Lanzhou, China
- 3Lanzhou Institute of Husbandry and Pharmaceutical Sciences, Chinese Academy of Agricultural Sciences, Lanzhou, China
- 4Medicine and Engineering Interdisciplinary Research Laboratory of Nursing & Materials/Nursing Key Laboratory of Sichuan Province, West China Hospital, West China School of Nursing, Sichuan University, Chengdu, Sichuan, China
- 5Department of Cell Biology, School of Life Sciences, Central South University, Changsha, China
- 6Department of Clinical Laboratory Sciences, College of Applied Medical Sciences, King Khalid University, Abha, Saudi Arabia
- 7Department of Clinical Laboratories Sciences, College of Applied Medical Sciences, Taif University, Taif, Saudi Arabia
Introduction: Dairy animals are continually at risk of infection due to exposure to contaminated environments, particularly through feed and water. The presence of Salmonella spp. and Escherichia coli in these sources poses a serious One Health concern due to their potential for antimicrobial resistance (AMR) and subsequent transmission to humans, animals, and the environment. This study was conducted to evaluate the prevalence of these pathogens and their resistance patterns in dairy farm feed and water samples.
Materials and methods: A total of 160 samples, comprising 98 feed and 49 water samples, were collected from dairy farms. Isolates were identified using Gram staining, motility testing, and endospore staining, followed by confirmation with standard biochemical tests (IMViC). Antimicrobial susceptibility testing was carried out, and Multiple Antibiotic Resistance Index (MARI) values were calculated.
Results: Of the 144 analyzable samples, 76 (51.7%) tested positive for E. coli and 68 (46.3%) for Salmonella spp. E. coli showed the highest susceptibility to ampicillin, cefotaxime, and ciprofloxacin (19%), while Salmonella spp. demonstrated the highest susceptibility to cefpodoxime and ampicillin (17%). MARI values exceeding the 0.2 threshold were observed in 6 (7.8%) E. coli isolates and 4 (5.8%) Salmonella spp. isolates, suggesting high antibiotic exposure. The mean inhibition zones were 9.87 ± 6.16 mm for E. coli and 8.5 ± 5.34 mm for Salmonella spp., with minimal variation between the two species.
Conclusion: The comparable prevalence and resistance patterns of E. coli and Salmonella spp. in dairy farm feed and water highlight the risk of antimicrobial-resistant bacteria dissemination across human, animal, and environmental domains. These findings underscore the importance of integrated monitoring systems, judicious antibiotic use, and coordinated stewardship measures within the One Health framework.
1 Introduction
The widespread emergence of antimicrobial resistance (AMR) is a growing global health threat that extends beyond human medicine to encompass animal and environmental health. Ensuring the safety of animal feed and drinking water is critical, as contaminated sources can act as reservoirs and transmission routes for resistant pathogens, with major consequences for animal production, public health, and the economy (1). However, several welfare concerns remain unaddressed. Early weaning, still a widespread practice in the dairy industry, has been a longstanding challenge in recent years (2).
Animal feed and byproducts are frequently contaminated with bacterial pathogens, including Salmonella enterica, Staphylococcus aureus, Listeria monocytogenes, Clostridium spp., Aeromonas, and Campylobacter, with Salmonella spp. being the most detected (3). Such contamination poses additional risks in regions where surveillance systems are limited and antimicrobial use in farming is poorly regulated, such as in low- and middle-income countries like Pakistan (4–6).
Antimicrobials are essential for treating infections in both humans and animals; however, their excessive or inappropriate use disrupts natural microbiota and drives the selection of multidrug-resistant (MDR) bacteria (7, 8). While these agents reduced infectious disease mortality in the 20th century, their widespread use, particularly in livestock production, often at sub-therapeutic doses, has contributed to the global rise of resistance (9–12). Recent reports highlight the detection of resistant Escherichia coli and Salmonella spp. in food-producing animals and animal feed, underscoring the role of feed and water as potential sources and reservoirs of resistance (13). Regardless of its origin, antibiotic resistance has been increasing, and it is now projected to become one of the leading causes of death, potentially contributing to more than 10 million fatalities each year (14).
Recent incidents involving these bacterial isolates in companion animals and livestock have highlighted the need for increased monitoring studies in livestock (15). E. coli strains that produce β-lactamase enzymes are increasingly detected in food-producing animals, posing a potential risk as sources of infection or reservoirs that contribute to the transmission of these harmful bacteria (16). Salmonella spp. and E. coli have been found in animal feed in recent studies, and their AMR profiles have also been characterized (17).
The One Health approach provides a valuable framework to address this challenge, recognizing the interconnectedness of human, animal, and environmental health (18). Monitoring resistant Gram-negative bacteria in dairy feed and water is therefore critical to identify contamination pathways, inform stewardship strategies, and mitigate the spread of AMR in agricultural systems.
Accordingly, this study aimed to investigate the prevalence and antimicrobial resistance profiles of Gram-negative bacteria in dairy animal feed and drinking water. These microorganisms pose risks to both veterinary care and public health, as they can infect animals, contaminate feed and water, and serve as carriers of resistance genes, particularly in settings where hygiene and antimicrobial oversight remain limited.
2 Materials and methods
2.1 Ethics statement
Animal research was guided by the Guide for the Care and Use of Laboratory Animals, released by the Ministry of Science and Technology of the People's Republic of China, with all efforts made to decrease animal suffering. This study was funded by grants from the National Natural Science Foundation of China and the Agricultural Research System (CARS-37).
2.2 Sample collection
2.2.1 Feed samples
A total of 98 feed samples were collected from animal farms under aseptic conditions with assistance from farm staff and agricultural distributors. Sub-samples were proportionally selected according to the number of units in each batch, following established guidelines. Each sample was labeled, placed in sterile bags, and transported to the laboratory for analysis.
2.2.2 Drinking water samples
Forty-nine drinking water samples were aseptically collected from dairy animal troughs using sterile disposable containers. Samples were immediately placed in insulated boxes with ice packs and transported to the laboratory within 4 h for microbiological analysis.
2.2.3 Sample size justification
A total of 160 samples (98 feed and 49 water) were collected to ensure adequate representation across the sampled farms while remaining feasible given available resources. The sample size is consistent with previous studies investigating bacterial contamination in livestock feed and water.
2.3 Screening and isolation of microorganisms
Isolation of Salmonella spp. and Escherichia coli was performed following standard microbiological protocols (19). Primary inoculation was carried out on nutrient agar, MacConkey agar, eosin methylene blue (EMB) agar, Salmonella-Shigella (SS) agar, mannitol salt agar, and blood agar. Plates were incubated aerobically at 37 °C for 24 h. Colony morphology, Gram staining, and motility (hanging drop method) were assessed for preliminary identification.
2.3.1 Primary isolation and culture
Swab samples were inoculated onto nutrient agar, MacConkey agar, eosin methylene blue (EMB) agar, Salmonella/Shigella (SS) agar, mannitol salt agar (MSA), and blood agar, and incubated aerobically and anaerobically at 37 °C for 24 h. Colony characteristics were recorded, and Gram-stained smears were prepared for preliminary identification (20).
2.3.2 Sub-culturing and identification
Suspicious colonies were further purified by repeated sub-culturing onto selective and differential media. Pure isolates were confirmed by colony morphology, Gram reaction, and biochemical tests (catalase, oxidase, indole, coagulase, TSI, Simmons' citrate), as well as the analytical profile index (API).
For E. coli, lactose-fermenting colonies showing a green metallic sheen on EMB or pink colonies on MacConkey agar were further confirmed using API and standard biochemical assays. For Salmonella spp., colonies appearing colorless and transparent on SS agar were confirmed by API, biochemical assays, and Gram staining (8).
2.4 Microscopic analysis
2.4.1 Motility test (hanging drop method)
A loopful of inoculum from an isolated colony of each sample was prepared and examined under the microscope using the hanging drop technique.
2.4.2 Gram's staining
Gram staining was performed following the standard protocol recommended by the American Society for Microbiology (ASM) (21).
2.5 Biochemical tests
2.5.1 IMViC test
2.5.1.1 Indole test
Pure bacterial culture was introduced into tryptophan broth (HIMEDIA® Ref: M1339-500G) and incubated at 37 °C for 24 h. After incubation, Kovac's reagent (2–3 drops) was added to each tube, and the reaction was examined after 15 min (22).
2.5.1.2 Methyl-Red test
MR-VP broth (HIMEDIA® Ref: M070-500G) was inoculated with the test organism and incubated at 37 °C for 24 h. After incubation, 2–3 drops of methyl red indicator were added, and observations were made after 15 min (22).
2.5.1.3 VP test
Five test tubes, each labeled with a specific sample ID, were filled with VP broth (HIMEDIA® Ref: M070F-500G), inoculated with the respective cultures, and incubated at 37 °C for 24 h. After incubation, 2–3 drops of Barritt's reagent were added to each tube, and results were noted after 15 min.
2.5.1.4 Citrate test
The citrate utilization test was conducted using citrate agar slants (HIMEDIA® Ref: M099-500G). Bacterial cultures were streaked along the surface of the slants, and the tubes were incubated at 37 °C for 24 h (21).
2.6 Antibiotic susceptibility test
Antimicrobial susceptibility testing of the isolates was carried out using Mueller-Hinton agar following the modified Kirby-Bauer disc diffusion technique, based on Clinical Laboratory Standards Institute (CLSI) recommendations. Each bacterial isolate was evenly spread on separate nutrient agar plates, and antibiotic discs were placed onto the surface using a sterile applicator to ensure proper contact. The plates were incubated at 37 °C for 24 h. To detect extended-spectrum β-lactamase (ESBL) production, the double-disc synergy test was performed using cefotaxime and amoxicillin-clavulanate discs (23).
A total of ten antimicrobial agents were evaluated: ampicillin (AMC) 10 μg, augmentin (AUG) 30 μg, cefotaxime (CTX) 30 μg, cefpodoxime (CP) 10 μg, ceftazidime (CAZ) 30 μg, amoxicillin (AMX) 25 μg, cefuroxime (CXM) 30 μg, ciprofloxacin (CPX) 10 μg, tetracycline (TE) 30 μg, and streptomycin (STR) 10 μg. Interpretation of the inhibition zones was carried out following the Clinical Laboratory Standards Institute (CLSI) guidelines (23, 24).
2.7 Multiple Antibiotic Resistance Index (MARI) determination
The Multiple Antibiotic Resistance Index (MARI) for each isolate was calculated using the formula: MARI
Where a is the number of antibiotics to which the isolate was resistant, and b is the total number of antibiotics tested. An MARI value >0.2 indicates that the isolate likely originated from an environment with high antibiotic use, suggesting potential multiple resistance traits. The 0.2 threshold is widely used in studies and aligns with guidelines from public health agencies to identify high-risk resistance profiles (25).
2.8 Statistical analysis
Graphs were generated using Microsoft Office Excel 2007. Descriptive statistical analysis was performed, including calculations of mean, standard deviation, frequencies, and percentages. The data were first assessed for normal distribution to determine the appropriate statistical tests for significance analysis. Mean values were also used to calculate the Multiple Antibiotic Resistance Index (MARI) scores.
3 Results
3.1 Confirmation of bacterial isolates
A total of 160 samples of water and animal feed were analyzed. Although the number of samples was somewhat limited, the sample size remains substantial. Feed samples (n = 98) and animal drinking water samples (n = 49) were collected across all targeted animal species (Table 1).
Overall, 71 samples (44.3%) tested positive for Salmonella spp., and 79 samples (49.3%) tested positive for E. coli. These findings suggest significant contamination at several sampling sites, with E. coli being the most frequently identified organism. At every critical sampling point, the levels of pathogenic bacterial contamination in both drinking water and animal feed were notably high. The highest contamination levels were observed in cattle and buffalo feed and water samples, whereas the lowest were found in sheep and goat samples. As shown in Table 1 and Figure 1, the variation in Salmonella spp. Isolation rates between farms (critical sampling points) were statistically significant.
3.2 Streak plate method
Colony morphology observations indicated the presence of a single bacterial type in the samples. Pigment formation was observed in some plates, as illustrated in Figure 2.
Figure 2. (A) Escherichia coli colonies and (B) Salmonella spp. colonies cultured on selective agar plates.
3.2.1 Microscopic analysis
3.2.1.1 Motility test
The motility test results showed that selected bacterial isolates from each sample exhibited motility, and all motile organisms were identified as rod-shaped. Under 10X and 100X magnification in an endospore stain, E. coli and Salmonella appeared as pink, rod-shaped cells, with no green endospores visible. Since E. coli is a non-endospore-forming bacterium, only the vegetative cells will be observed. At 10X, we can see the overall distribution of the bacterial cells, while at 100X, individual pink rods were visible under oil immersion, but no green spore structures were present. Samples appeared pink in color, indicating a Gram-negative nature.
3.3 IMViC test results
The IMViC test is a series of biochemical tests used to help identify and differentiate members of the Enterobacteriaceae family, particularly Escherichia coli (E. coli), from other coliforms and enteric bacteria, such as Salmonella. The results of the IMViC biochemical tests are summarized in Table 2.
3.3.1 Indole test
The indole test is used to assess an organism's ability to break down the amino acid tryptophan and produce indole. Escherichia coli served as the positive control, while Bacillus subtilis was used as the negative control. In the positive control, a cherry-red ring developed at the surface of the medium, whereas no color change was observed in the negative control. A pink to red layer appeared in the test samples above the medium, indicating a positive indole reaction. These results suggest that all the bacterial isolates tested could produce indole.
3.3.2 Methyl Red test (MR)
The Methyl Red (MR) test assesses an organism's ability to perform mixed-acid fermentation of glucose, leading to the formation of stable acidic end products. The procedure involves inoculating the test organism into MR-VP broth, followed by incubation at 37 °C for 24 to 48 h. After incubation, Methyl Red indicator is added. A red coloration signifies a pH below 4.4, indicating a positive result for mixed-acid fermentation. In contrast, a yellow or orange color suggests a higher pH and a negative result.
3.3.3 Voges-Proskauer test
The Voges-Proskauer (VP) test detects the production of acetoin, a neutral intermediate formed during butylene glycol fermentation of glucose. This test identifies whether an organism can ferment glucose to produce acetyl methyl carbinol (acetoin). Escherichia coli was used as both the positive and negative control for comparison. Upon analysis, the appearance of a red or pink color indicated a positive result. Based on the observed results, all tested samples showed a positive VP reaction, suggesting that they produce acetoin during glucose fermentation.
3.3.4 Citrate utilization test
Determines the ability of an organism to use citrate as its sole carbon source, converting it into alkaline products (such as ammonia). Inoculate the bacteria onto Simmons' Citrate Agar (or another citrate medium). Incubate at 37 °C for 24–48 h. A color change from green to blue, indicating alkalinization due to citrate utilization. No color change (the medium remains green), indicating the organism cannot utilize citrate. The results of the IMViC biochemical tests are summarized in Table 2.
The IMViC test series is a simple and reliable method for identifying and differentiating enteric bacteria based on their biochemical characteristics. By analyzing the results, laboratories can classify organisms, facilitating accurate identification, especially in clinical microbiology.
3.4 Antimicrobial susceptibility of the bacterial isolates
Antibiogram analysis indicated that antibiotics were generally effective against both Gram-positive and Gram-negative bacteria. However, Salmonella spp. and environmental E. coli strains isolated from drinking water and animal feed showed signs of antibiotic resistance. Resistance to ten different antibiotics was detected among the isolates, suggesting widespread contamination with varying resistance profiles. Overall, E. coli was the most frequently isolated bacterium, while Salmonella spp. demonstrated relatively high antibiotic susceptibility (Tables 3, 4, and Figure 3).

Table 3. Antibiotic sensitivity of gram-negative E. coli (n = 76) isolates from animal feed and water samples.

Table 4. Antibiotic sensitivity of gram-negative bacterial Salmonella spp. (n = 68) isolates from animal feed and water samples.
3.5 Resistance rates and Multiple Antibiotic Resistance Index (MARI) of bacterial isolates
The susceptibility of bacterial isolates to 10 antibiotics was assessed by measuring inhibition zone diameters. Both E. coli and Salmonella spp. demonstrated resistance to multiple antibiotics. Specifically, E. coli isolates were resistant to six antibiotics, while Salmonella spp. Isolates were resistant to four. Both species remained highly susceptible to ampicillin, cefpodoxime, cefotaxime, ciprofloxacin, Augmentin, and streptomycin (Table 5).
Multidrug resistance was evaluated using the Multiple Antibiotic Resistance Index (MARI), calculated as the ratio of the number of antibiotics to which an isolate was resistant to the total number tested (n = 10). E. coli isolates exhibited a higher MARI (0.6), indicating exposure to environments with high antibiotic use and potential multi-resistance, whereas Salmonella spp. showed moderate resistance with a MARI of 0.4.
Table 6 shows the mean ± standard deviation (SD) of inhibition zone diameters for each species. E. coli demonstrated slightly higher resistance levels compared to Salmonella spp., although differences were minimal. These findings highlight the presence of multidrug-resistant bacteria in the sampled feed and water source.
4 Discussion
Dairy animals are extensively studied in animal welfare, yet challenges such as early weaning persist (2, 26). In this study, we analyzed the prevalence and multidrug resistance (MDR) patterns of Salmonella spp. and E. coli in water and animal feed samples. E. coli was the most frequently isolated species (51.7%), followed by Salmonella spp. (46.3%), consistent with previous reports in livestock and feed (27).
Our findings revealed resistance to multiple beta-lactam antibiotics in both E. coli and Salmonella, with intermediate resistance observed for ciprofloxacin, tetracycline, cefixime, and cefuroxime. These patterns align with studies from Pakistan and neighboring countries, highlighting the widespread presence of MDR pathogens in livestock environments (28), these results are consistent with those of the current investigation. Similarly, high levels of E. coli were found in Jordanian cows (29). These findings are consistent with recent studies that identified E. coli as the most common species in healthy animals (30).
A series of biochemical tests was conducted to characterize the bacterial isolates from the samples. The hanging drop technique was employed to observe bacterial motility, as well as to examine the size, shape, and cellular arrangement of the organisms (31).
The IMViC test provides a useful method to differentiate E. coli from Salmonella. While both are gram-negative, facultative anaerobes, E. coli tends to be indole-positive, methyl red-positive, and citrate-negative, while Salmonella is indole-negative, methyl red-positive, and citrate-positive. The differences in citrate utilization are particularly key, as Salmonella can thrive on citrate, whereas E. coli cannot. These tests help in confirming the identity of these pathogens in microbiological investigations (32, 33). Previous research has shown that extensive investigations into the biochemical characteristics of bacteria have been conducted to develop biochemical typing systems, which play a crucial role in the epidemiological tracking and identification of bacterial strains (34).
The VP test determines whether organisms produce acetyl methyl carbinol by fermenting glucose (35). Bacillus subtilis and E. coli were used as the positive and negative controls, respectively, for the Voges-Proskauer (VP) test. Upon analysis of the test results, no development of the characteristic red or pink color was observed in any of the samples, indicating that all tested isolates were negative for acetoin production.
The antibiotics with the highest sensitivity rates in E. coli isolates in this study were ampicillin, cefpodoxime, cefotaxime, and ciprofloxacin (25 and 19%), followed by streptomycin and Augmentin (24 and 18.4%). These findings align with previous studies, which have reported a rapid increase in antibiotic resistance, particularly in E. coli strains isolated from animals (36, 37). The highest resistance to doxycycline was observed in E. coli. In comparison, resistance rates for gentamicin were 66%, tetracycline 72%, ampicillin 85%, and amoxicillin + clavulanic acid 58% (25, 38).
However, Salmonella spp. had the highest rate of amoxicillin resistance in this study 50%. Several researchers from Ethiopia reported antibiotic-resistant Salmonella isolates from feed in previous studies (39), and from other countries. A previous study reported that Salmonella spp. isolates exhibited resistance to nalidixic acid 78.57%, tetracycline 42.58%, and ampicillin 42.58% (40); Similarly, a large percentage of Salmonella isolates, 100% were shown to be resistant to ampicillin in another investigation (8, 41).
The highest number of isolates for both Salmonella spp. and E. coli was found in the animal feed and water. This type of feed is intended for direct consumption, but its production is often less regulated compared to other forms of feed and may not adhere to commercial standards. The feed is typically produced through mechanical homogenization, with high temperatures rarely used. Potential contributing factors to contamination include inadequate cleaning of production lines, poor rodent control, improper storage on floors rather than in designated food storage areas, and substandard packaging and storage conditions (42, 43).
The Multiple Antibiotic Resistance Index (MARI) among isolates ranged from 0.06 to 0.07, indicating moderate exposure to antibiotics, in contrast to earlier overstated values. High MARI values, even at this level, suggest ongoing selective pressure due to antibiotic use in farms and underscore the risk of MDR dissemination through feed and water (44).
Our findings of an average MARI of 0.8 exceed those reported in similar studies in Ghana (0.11– 0.78) and South Africa (0.3–0.6), further underscoring the severity of antibiotic misuse in the sampled farms. These elevated MARI values not only pose a threat to animal health but also carry significant (20). One Health implications, as they indicate a heightened risk of antimicrobial resistance transmission among animals, humans, and the environment (45).
Contamination in feed and water likely arises from inadequate hygiene during production, storage, and handling, consistent with previous reports. These findings emphasize the importance of strict biosecurity measures, proper feed management, and monitoring of antibiotic use to prevent the spread of resistant bacteria (46).
Comparisons with global surveillance programs, including WHO and national monitoring systems, show similar resistance trends in E. coli and Salmonella isolates from food-producing animals (47, 48). This underscores the One Health implications of antimicrobial resistance, highlighting potential transmission between animals, humans, and the environment. It has documented high levels of multidrug resistance in E. coli and Salmonella from food-producing animals in several regions. Similarly, the U.S. National Antimicrobial Resistance Monitoring System (30, 49) reports comparable resistance trends, and national surveillance reports from Pakistan (2022) and China (2023) show elevated MARI values and widespread resistance to beta-lactam and tetracycline-class antibiotics in livestock environments (50, 51).
Although our sample size was sufficient, the relatively small number of positive samples limited additional statistical analyses. Future studies should include molecular characterization of resistance genes to better understand the mechanisms underlying MDR in livestock environments.
In conclusion, our results highlight the prevalence of E. coli and Salmonella in dairy feed and water, their multidrug resistance patterns, and the need for improved antimicrobial stewardship and hygiene practices in livestock production.
5 One Health integration
Our study highlights the interconnectedness of animal, environmental, and human health through the lens of antimicrobial resistance (AMR). The presence of resistant E. coli and Salmonella in animal feed and water not only affects livestock health but also poses risks to humans, particularly farm workers who have direct occupational exposure to these bacteria. Moreover, consumption of contaminated milk and dairy products can be a direct route for transmitting resistant pathogens to consumers, posing a significant public health concern.
To address these challenges, we propose a One Health surveillance model that includes regular monitoring of livestock health and bacterial resistance patterns, environmental sampling of soil and water runoff to detect contamination sources, and, where ethically permissible, screening of human handlers for colonization or infection with resistant bacteria. This integrated approach can enhance early detection, improve risk assessment, and inform coordinated interventions to control the spread of AMR in the region.
6 Significance and future directions
This study highlights the high prevalence of multidrug-resistant E. coli and Salmonella in dairy animal feed and water, underscoring the urgent need for targeted interventions to reduce antimicrobial misuse in livestock production. Future work should include molecular characterization of these isolates, such as detection and sequencing of specific resistance genes, to better understand the genetic determinants and potential for horizontal gene transfer. Longitudinal studies are essential to monitor resistance trends over time and assess the effectiveness of intervention strategies. Expanding surveillance to include environmental sources such as soil, manure, and farm runoff will provide a more comprehensive picture of AMR dissemination within and beyond farm boundaries. These findings also have important policy implications, supporting the development of farm-level AMR monitoring programs and strengthened antimicrobial stewardship frameworks that align with national and global One Health initiatives.
7 Conclusion
The high prevalence of antimicrobial-resistant Gram-negative bacteria in dairy animal feed and water poses a serious threat to both animal and public health. This resistance is likely driven by factors such as poor sanitation, overuse of antibiotics, and environmental contamination. The detection of multidrug-resistant strains highlights the urgent need for stricter regulations on antibiotic use in livestock farming. To address this challenge, regular monitoring, improved hygiene, antimicrobial stewardship programs, and sustainable alternatives to antibiotics should be implemented. Strengthening policies and veterinary diagnostic capabilities, along with raising public awareness about responsible antibiotic use, are essential steps to reduce antimicrobial resistance. Future research should focus on understanding resistance mechanisms and developing effective control strategies. Immediate action is crucial to safeguard animal welfare and prevent the spread of antimicrobial resistance.
Data availability statement
The original contributions presented in the study are included in the article/supplementary material, further inquiries can be directed to the corresponding author.
Author contributions
SA: Writing – original draft, Writing – review & editing. HU: Writing – review & editing. WW: Writing – review & editing. AQ: Writing – review & editing. AA: Writing – review & editing. FA: Writing – review & editing. KJA: Writing – review & editing. KFA: Writing – review & editing. JZ: Writing – review & editing.
Funding
The author(s) declare that financial support was received for the research and/or publication of this article. This work was supported by the earmarked funds for the Science and Technology plan Project of Gansu Province (No. 23ZDFA001) and China Agriculture Research System (CARS-37). The authors also thank the Deanship of Scientific Research at King Khalid University for funding through the Large Research group Project grant (No. RGP.02/729/46).
Conflict of interest
The authors declare that the research was conducted in the absence of any commercial or financial relationships that could be construed as a potential conflict of interest.
Generative AI statement
The author(s) declare that no Gen AI was used in the creation of this manuscript.
Any alternative text (alt text) provided alongside figures in this article has been generated by Frontiers with the support of artificial intelligence and reasonable efforts have been made to ensure accuracy, including review by the authors wherever possible. If you identify any issues, please contact us.
Publisher's note
All claims expressed in this article are solely those of the authors and do not necessarily represent those of their affiliated organizations, or those of the publisher, the editors and the reviewers. Any product that may be evaluated in this article, or claim that may be made by its manufacturer, is not guaranteed or endorsed by the publisher.
References
1. Arbab S, Ullah H, Wang W, Zhang J. Antimicrobial drug resistance against Escherichia coli and its harmful effect on animal health. Vet Med Sci. (2022) 8:1780–86.
2. Cantor MC, Neave HW, Costa JH. Current perspectives on the short-and long-term effects of conventional dairy calf raising systems: a comparison with the natural environment. Trans Animal Sci. (2019) 3:549–63. doi: 10.1093/tas/txy144
3. Abdullah RM, Ali S, Aslam B, Arshad MI. Molecular characterization and drug resistance pattern of Pseudomonas aeruginosa isolated from poultry meat and meat products. Pakis Vet J. (2024) 44.
4. Abd-Elfatah EB, Fawzi EM, Elsheikh HA, Shehata AA. Prevalence, virulence genes and antibiogram susceptibility pattern of Staphylococcus aureus and Streptococcus agalactiae isolated from mastitic ewes. Int J Vet Sci. 12:152–60.
5. Liu J, Zhang X, Niu J, Han Z, Bi C, Mehmood K, et al. Complete genome of multi-drug resistant Staphylococcus aureus in bovine mastitic milk in Anhui, China. Pakis Vet J. (2023) 43.
6. Arbab S, Ullah H, Bano I, Li K, Ul Hassan I, Wang W, et al. Evaluation of in vitro antibacterial effect of essential oil and some herbal plant extract used against mastitis pathogens. Vet Med Sci. (2022) 8:2655–61. doi: 10.1002/vms3.959
7. Berghiche A, Khenenou T, Kouzi A, Labiad I. An investigation on the predominant diseases, its diagnosis, and commonly used drugs in the poultry farms in the North-Eastern regions of Algeria. Vet World. (2018) 11:986. doi: 10.14202/vetworld.2018.986-989
8. Arbab S, Buriro RS, Ullah H, Bhugio SU, Shah AH, Kalho DH, et al. Comparison of antibacterial activity of Ciprofloxacin and Cephalexin against Some common bacterial Species isolates from donkey wounds around the vicinity of Tandojam Sindh Pakistan. Pure Appl Biol 10:1095–103. doi: 10.19045/bspab.2021.100114
9. Ullah H, Arbab S, Chang C, Bibi S, Hassan IU, Tian Y, et al. Gut microbiota therapy in gastrointestinal diseases. Front Cell Dev Biol. (2025) 13:1514636. doi: 10.3389/fcell.2025.1514636
10. Ullah H, Arbab S, Tian Y, Liu C-Q, Chen Y, Qijie L, et al. The gut microbiota–brain axis in neurological disorder. Front Neurosci. (2023) 17:1225875. doi: 10.3389/fnins.2023.1225875
11. Ullah H, Arbab S, Tian Y, Chen Y, Liu C-Q, Li Q, et al. Crosstalk between gut microbiota and host immune system and its response to traumatic injury. Front Immunol. (2024) 15:1413485. doi: 10.3389/fimmu.2024.1413485
12. Arbab S, Ullah H, Weiwei W, Wei X, Ahmad SU, Wu L, et al. Comparative study of antimicrobial action of aloe vera and antibiotics against different bacterial isolates from skin infection. Vet Med Sci. (2021) 7:2061–7. doi: 10.1002/vms3.488
13. Wu X, Wang Y, Wang Q, Wang Y, Wang H, Luo X. Acinetobacter of pigs reveals high multiple drug resistance through genomics and antimicrobial resistance monitoring. Pakistan Vet J. (2024) 44.
14. de Kraker ME, Stewardson AJ, Harbarth S. Will 10 million people die a year due to antimicrobial resistance by 2050? PLoS Med. (2016) 13:e1002184. doi: 10.1371/journal.pmed.1002184
15. Smet A, Van Nieuwerburgh F, Vandekerckhove TT, Martel A, Deforce D, Butaye P, et al. Complete nucleotide sequence of CTX-M-15-plasmids from clinical Escherichia coli isolates: insertional events of transposons and insertion sequences. PLoS ONE. (2010) 5:e11202. doi: 10.1371/journal.pone.0011202
16. Arbab S, Ullah H, Wang W, Zhang J. Antimicrobial drug resistance against Escherichia coli and its harmful effect on animal health. Vet Med Sci. 8:1780–6. doi: 10.1002/vms3.825
17. Issa NA. Evaluation the antimicrobial activity of essential oils against veterinary pathogens, multidrug-resistant bacteria and dermatophytes. Pakistan Vet J. (2024) 44.
18. Arbab S, Ullah H, Hassan IU, Suleman, Wang W, Qadeer A, et al. Prevalence and molecular characterization of cystic echinococcosis in livestock in the Hazara Division, Pakistan. Front Vet Sci. (2025) 12:1542572. doi: 10.3389/fvets.2025.1542572
19. Peruzy MF, Houf K, Joossens M, Yu Z, Proroga YTR, Murru N. Evaluation of microbial contamination of different pork carcass areas through culture-dependent and independent methods in small-scale slaughterhouses. Int J Food Microbiol. (2021) 336:108902. doi: 10.1016/j.ijfoodmicro.2020.108902
20. Arbab S, Ullah H, Wang W, Li K, Akbar A, Zhang J. Isolation and identification of infection-causing bacteria in dairy animals and determination of their antibiogram. J Food Qual. (2021) 2021:2958304. doi: 10.1155/2021/2958304
21. Wijesinghe Y, Kanagaraju M, Arambage M. Isolation and biochemical characterization of bacteria in processed chicken meat balls and determination of antibiotic susceptibility. (2024) 2.
22. Islam S, Oni AI. Biomedical Waste in Healthcare: A Comprehensive Study on Microbial Analysis, Radioactive Analysis and Prevalence of Opportunistic Bacteria. Brac University. (2024).
23. Wayne P. Clinical and laboratory standards institute. Performance Standards for Antimicrobial Susceptibility Testing. (2011) 31:100–21.
24. Humphries RM, Ferraro MJ, Hindler JA. Impact of 21st Century Cures Act on breakpoints and commercial antimicrobial susceptibility test systems: progress and pitfalls. J Clin Microbiol. (2018) 56:e00139-18. doi: 10.1128/JCM.00139-18
25. Arbab S, Ullah H, Wei X, Wang W, Ahmad S, Zhang J. Drug resistance and susceptibility testing of Gram negative bacterial isolates from healthy cattle with different β-Lactam resistance Phenotypes from Shandong province China. Braz J Biol. (2021) 83:e247061. doi: 10.1590/1519-6984.247061
26. Fujita AW, Werner K, Jacob JT, Tschopp R, Mamo G, Mihret A, et al. Antimicrobial resistance through the lens of one health in Ethiopia: a review of the literature among humans, animals, and the environment. Int J Infect Dis. (2022) 119:120–9. doi: 10.1016/j.ijid.2022.03.041
27. Jia D, Arbab S, Ullah H, Alzahrani KJ, Alzahrani FM, Alsharif KF, et al. Antibacterial activity of traditional medicinal plants: combating antibiotics resistance in animal wound infections. Vet Med Sci. (2025) 11:e70361. doi: 10.1002/vms3.70361
28. Oloso NO, Fagbo S, Garbati M, Olonitola SO, Awosanya EJ, Aworh MK, et al. Antimicrobial resistance in food animals and the environment in Nigeria: a review. Int J Environ Res Public Health. (2018) 15:1284. doi: 10.3390/ijerph15061284
29. Zhang D, Zhang Z, Huang C, Gao X, Wang Z, Liu Y, et al. The phylogenetic group, antimicrobial susceptibility, and virulence genes of Escherichia coli from clinical bovine mastitis. J Dairy Sci. (2018) 101:572–80. doi: 10.3168/jds.2017-13159
30. Mwafy A, Youssef DY, Mohamed MM. Antibacterial activity of zinc oxide nanoparticles against some multidrug-resistant strains of Escherichia coli and Staphylococcus aureus. Int J Vet Sci. (2024) 12:284–9. doi: 10.47278/journal.ijvs/2022.181
31. Tanzin D, Binte Farooq F, Zahedy SF, Baidya P, Brinto TT, Mim MM. Isolation and Characterization of Bacteria From Burn-Injured Patients and Detection of Their Antibiotic Sensitivity Pattern. Brac University. (2022).
32. Seddoh A, Onyeze A, Gyapong JO, Holt J, Bundy D. Towards an investment case for neglected tropical diseases. Lancet. (2013) 9908:1898–955.
33. Azam SE, Yasmeen F, Rashid MS, Ahmad U, Hussain S, Perveez A, et al. Silver nanoparticles loaded active packaging of low-density polyethylene (LDPE), a challenge study against Listeria monocytogenes, Bacillus subtilis and Staphylococcus aurerus to enhance the shelf life of bread, meat and cheese. Int J Agri Biosci. (2023) 12:165–71.
34. Katouli M, Khn I, Mllby R. Evaluation of the stability of biochemical phenotypes of Escherichia coli upon subculturing and storage. Microbiology. (1990) 136:1681–8. doi: 10.1099/00221287-136-9-1681
35. Al-Mozan HDK. Gene of 16S rRNA is the gold standard to diagnose bacteria. World J. Curr. Med. Pharm. Res. (2023) 5:139–78. doi: 10.37022/wjcmpr.v5i4.283
36. Ogunleye AO, Oyekunle MA, Sonibare AO. Multidrug resistant Escherichia coli isolates of poultry origin in Abeokuta, South Western Nigeria. Veterinarski Arhiv. (2008) 78:501–9.
37. Xiong J, Chen F, Zhang J, Ao W, Zhou X, Yang H, et al. Occurrence of aflatoxin M1 in three types of milk from Xinjiang, China, and the risk of exposure for milk consumers in different age-sex groups. Foods. (2022) 11:3922. doi: 10.3390/foods11233922
38. Huang Z, Xiao F, Wang Q, Zhang X, Shen Y, Deng Y, et al. BSC2 modulates AmB resistance via the maintenance of intracellular sodium/potassium ion homeostasis in Saccharomyces cerevisiae. Res Microbiol. (2024) 175:104245. doi: 10.1016/j.resmic.2024.104245
39. Molla B, Alemayehu D, Salah W. Sources and distribution of Salmonella serotypes isolated from food animals, slaughterhouse personnel and retail meat products in Ethiopia: 1997-2002. Ethiopian J Health Dev. (2003) 17:63–70. doi: 10.4314/ejhd.v17i1.9782
40. Addis Z, Kebede N, Sisay Z, Alemayehu H, Wubetie A, Kassa T. Prevalence and antimicrobial resistance of Salmonella isolated from lactating cows and in contact humans in dairy farms of Addis Ababa: a cross sectional study. BMC Infect Dis. (2011) 11:1–7. doi: 10.1186/1471-2334-11-222
41. Tajbakhsh F, Tajbakhsh E, Momeni M, Rahimi E, Sohrabi R. Occurrence and antibiotic resistance of Salmonella spp Isolated from raw cow's milk from Shahahrekord, Iran. Int J Microbiol Res. (2012) 3:242–5.
42. Munoz L, Pacheco W, Hauck R, Macklin K. Evaluation of commercially manufactured animal feeds to determine presence of Salmonella, Escherichia coli, and Clostridium perfringens. J Appl Poul Res. (2021) 30:100142. doi: 10.1016/j.japr.2021.100142
43. Almansour AM, Alhadlaq MA, Alzahrani KO, Mukhtar LE, Alharbi AL, Alajel SM. The silent threat: antimicrobial-resistant pathogens in food-producing animals and their impact on public health. Microorganisms. (2023) 11:2127. doi: 10.3390/microorganisms11092127
44. Krumperman PH. Multiple antibiotic resistance indexing of Escherichia coli to identify high-risk sources of fecal contamination of foods. Appl Environ Microbiol. (1983) 46:165–70. doi: 10.1128/aem.46.1.165-170.1983
45. Mustapha A, Isa MA, Isa T, Ngoshe IY, Bala H. Detection of multidrug resistant gram negative bacteria in healthy cattle from maiduguri metropolitan, Nigeria. J Adv Microbiol. (2020) 20:68–76. doi: 10.9734/jamb/2020/v20i630255
46. Mthembu TP, Zishiri OT, El Zowalaty ME. Molecular detection of multidrug-resistant Salmonella isolated from livestock production systems in South Africa. Infect Drug Resist. (2019) 12:3537–48. doi: 10.2147/IDR.S211618
47. Kusuma IY, Octaviani P, Nurkholis F, Prabandari R, Derek R, Sariati Y. The role of GLASS (global health through sustainable antimicrobial resistance surveillance) in combatting antimicrobial resistance: challenges and strategies. (2025) EDP Sci. 152:16. doi: 10.1051/bioconf/202515201003
48. Collignon PJ, McEwen SA. One health—its importance in helping to better control antimicrobial resistance. Trop Med Infect Dis. (2019) 4:22. doi: 10.3390/tropicalmed4010022
49. Havas K, Edler R, Ruesch L, Braun M, Ferm P, Noyes NR, et al. Assessment of a monitoring program of pig farms' antimicrobial purchase and resistance monitoring program for Escherichia coli and Salmonella enterica in the Midwestern United States, May 2020 through October 2023. Front Vet Sci. (2025) 12:1586008. doi: 10.3389/fvets.2025.1586008
50. Qiu Y, Ferreira JP, Ullah RW, Flanagan P, Zaheer MU, Tahir MF, et al. Assessment of the implementation of Pakistan's national action plan on antimicrobial resistance in the agriculture and food sectors. Antibiotics 13:206. (2024). doi: 10.3390/antibiotics13030206
Keywords: antimicrobial resistance, antibiotic resistance index, One Health, farm-level surveillance, hygiene practices, regulatory measures
Citation: Arbab S, Ullah H, Wang W, Qadeer A, Aseeri AA, Alzahrani FM, Alzahrani KJ, Alsharif KF and Zhang J (2025) Prevalence and antimicrobial drug resistance of gram-negative bacteria in dairy feed and water: a One Health concern. Front. Vet. Sci. 12:1654200. doi: 10.3389/fvets.2025.1654200
Received: 14 July 2025; Accepted: 25 August 2025;
Published: 24 September 2025.
Edited by:
Mughees Aizaz Alvi, University of Agriculture, Faisalabad, PakistanReviewed by:
Abba Salisu, Bayero University Kano, NigeriaAshiq Ali, Shantou University, China
Gaurav Chhetri, The State University of New York, United States
Copyright © 2025 Arbab, Ullah, Wang, Qadeer, Aseeri, Alzahrani, Alzahrani, Alsharif and Zhang. This is an open-access article distributed under the terms of the Creative Commons Attribution License (CC BY). The use, distribution or reproduction in other forums is permitted, provided the original author(s) and the copyright owner(s) are credited and that the original publication in this journal is cited, in accordance with accepted academic practice. No use, distribution or reproduction is permitted which does not comply with these terms.
*Correspondence: Jiyu Zhang, aW5memp5QHNpbmEuY29t; Hanif Ullah, ZHIuaGFuaWZ1bGxhaDM2N0BnbWFpbC5jb20=
 Safia Arbab
Safia Arbab Hanif Ullah
Hanif Ullah Weiwei Wang
Weiwei Wang Abdul Qadeer
Abdul Qadeer Abdullah A. Aseeri6
Abdullah A. Aseeri6 Khalid J. Alzahrani
Khalid J. Alzahrani Khalaf F. Alsharif
Khalaf F. Alsharif Jiyu Zhang
Jiyu Zhang




